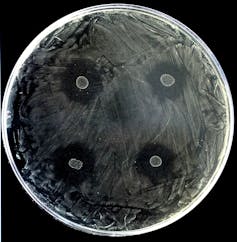

¿Qué microorganismos compartimos al besarnos?
Jéssica Gil Serna, Universidad Complutense de Madrid y Alejandro Mira Obrador, Fisabio
Un beso puede ser fruto del cariño o la pasión pero ¿qué ofrecemos a la pareja que besamos? A veces, simplemente nos dejamos llevar pensando que solo compartimos amor, pero hay algo de lo que quizás no nos estemos percatando… ¡también intercambiamos muchos microorganismos!
Aunque no lo parezca, la boca es un complejo ecosistema donde pueden vivir hasta 700 especies de bacterias. Sus condiciones lo permiten: la saliva hace que sea un ambiente húmedo, tiene una temperatura moderada y un suministro constante de nutrientes. Por eso, es un sitio ideal para que crezcan bacterias.
Como la boca está llena de microorganismos, es evidente que podemos intercambiar muchos de ellos al besarnos. De hecho, según un estudio holandés realizado con estudiantes, en un beso apasionado de 10 segundos nos transferimos la friolera cantidad de 80 millones de bacterias.
¿Quién vive alrededor de nuestra lengua?
La comunidad de bacterias de la boca es lo que se conoce como microbiota oral y nos acompaña desde el nacimiento. A lo largo de la vida se va modificando en función de lo que comemos, si tomamos medicamentos o no, nuestra higiene o si fumamos. La edad y la genética también influyen en la composición de esta microbiota.
En general, las bacterias que viven en la boca aportan muchos beneficios. No dejan hueco para que puedan colonizar patógenos, ayudan con la digestión y mantienen alerta al sistema inmunitario. Además, algunas producen vasodilatadores que ayudan a regular la presión arterial.
Viven en comunidades en distintas partes de la boca, formando biopelículas. Producen una matriz pegajosa que las ancla al sustrato y así quedan protegidas de las inclemencias del ambiente, como los anticuerpos o los antibióticos.
Estas complejas comunidades pueden establecerse en los dientes, las encías o la lengua. En otras partes como las mejillas no da tiempo a que se formen estas biopelículas porque las células de la mucosa se renuevan muy rápido.
Cada zona tiene unas condiciones diferentes de oxígeno y nutrientes, lo que hace que la comunidad bacteriana cambie mucho. Ni siquiera es igual entre la parte de delante y trasera del mismo diente. Tanto es así que la microbiota de su lengua probablemente sea más semejante a la de un desconocido que a la de sus propios dientes.
Mucho más que un simple beso
El contacto estrecho que exige un beso hace que las bacterias pasen fácilmente de una boca a otra. Pensarlo produce bastante repelús pero la mayoría son transitorias y, tal cual llegan, las tragamos o las eliminamos sin darnos cuenta.
La capacidad de las bacterias para establecerse en la boca depende de si pueden adherirse a alguna de sus superficies o no. Además, el sistema inmunitario no se lo pone fácil ya que la saliva concentra un tipo de anticuerpos llamados IgA, producidos por las mucosas, que intentan bloquear la adhesión de las bacterias. Como apunte: las personas que tienen más caries presentan menores niveles de este anticuerpo.
Por tanto, aunque con un beso lleguen muchas bacterias de nuestra pareja, la mayoría pasan directamente hacia el intestino. Sin embargo, no hay que bajar la guardia. Algunas consiguen pegarse firmemente y se establecen en la boca.
Toda esta información nos dice que sería difícil que las bacterias colonizasen tras un beso. Pero hay que tener cuidado porque en la microbiota también se pueden esconder microorganismos que no son tan buenos. Vamos a verlos.
El lado oscuro de la microbiota oral
La biopelícula producida por las comunidades bacterianas sobre los dientes es lo que se conoce como placa dental. A veces es muy estable y se hace difícil de eliminar.
Las bacterias utilizan los azúcares de los alimentos y producen gran cantidad de ácidos. Estas condiciones hacen que el esmalte del diente pierda mineral, produciendo caries.

Por ello, el consumo de azúcar se relaciona directamente con el desarrollo de caries dental. Este hecho no es nada nuevo. Según registros de la Revolución Industrial, se produjo un aumento de la caries cuando en Inglaterra se eliminó el impuesto al azúcar y este pasó a ser de uso común.
Entre las bacterias más problemáticas encontramos Streptococcus mutans y algunas especies de Lactobacillus. También se ha caracterizado recientemente a Scardovia wiggsiae, una de las responsables de caries tempranas en niños.
¿Podemos reducir la comunidad de bacterias ‘malas’?
Si la placa dental no se elimina con regularidad, la inflamación que se genera en las encías puede ser irreversible, dañar el tejido que sostiene los dientes y producir periodontitis.
Estos casos se suele asociar fundamentalmente al desarrollo del “complejo rojo” formado por tres especies bacterianas, entre las que se encuentra Porphyromonas gingivalis. Esta bacteria manipula el sistema inmunitario y produce una toxina que se ha encontrado recientemente en cerebros post mortem de personas que padecían Alzheimer.
Por otro lado, no hay que olvidar algunas bacterias de la microbiota oral que se relacionan con la halitosis (mal aliento producido por la acumulación bacteriana). Estas bacterias suelen vivir en la lengua y producen compuestos volátiles derivados del azufre al fermentar proteínas de la dieta.
Por todo ello, la higiene es fundamental para reducir la incidencia de estas enfermedades orales. Con el lavado de dientes después de cada comida, se retira gran parte de la biopelícula de la placa dental y las bacterias tienen que trabajar para formarla de nuevo.
Además, lavarse los dientes favorece a las bacterias que necesitan oxígeno para crecer, que suelen ser beneficiosas. Incluso hay que cepillarse la lengua porque algunas de las causantes del sangrado de las encías se esconden ahí.
Compartir vida… y microbiota
En general, las parejas estables tienden a tener una microbiota oral bastante parecida. Cuantos más besos manifiestan darse, más similitud entre las bacterias que comparten. Aunque esto, a simple vista, puede parecer romántico, también tiene un aspecto negativo. Con el tiempo, las personas con enfermedad periodontal pueden transmitir algunas de las bacterias perjudiciales a sus parejas.
Este es el caso de la temida Aggregatibacter actinomycetencomitans. Los odontólogos la llaman cariñosamente “AA” y tiene una facilidad particular para transmitirse.
Sin embargo, compartir microbiota con nuestra pareja también puede tener efectos anticaries. La presencia en la boca de Streptococcus dentisani ha demostrado proteger efectivamente frente a estas enfermedades. Esta bacteria está presente hasta en el 99 % de individuos sanos libres de caries y en mayores niveles que en personas con caries.
Cuando uno de los miembros de una pareja estable presenta Streptococcus dentisani en su boca, se la transmite a su pareja, promoviendo su salud dental. Actualmente, se trabaja para desarrollar un producto con esta bacteria probiótica para poder implantarla y prevenir la caries.
Los primeros estudios clínicos a nivel mundial, realizados en Valencia, han dado resultados muy prometedores. Cuando se dan varias aplicaciones de la bacteria en un gel bucodental es posible reducir la placa dental y la inflamación.
Recordemos que los casos mencionados se relacionan solamente con la microbiota oral pero no hay que olvidar que los besos pueden transmitir gran cantidad de patógenos. Enfermedades respiratorias, herpes labial, candidiasis o paperas son una pequeña muestra.
Un beso es pura química. Produce la liberación de la oxitocina u “hormona del amor”, que despierta sentimientos de afecto y ayuda a mantener el vínculo de pareja. Eso sí, teniendo en cuenta todo lo anterior, elija bien con quien quiere compartir los microbios.